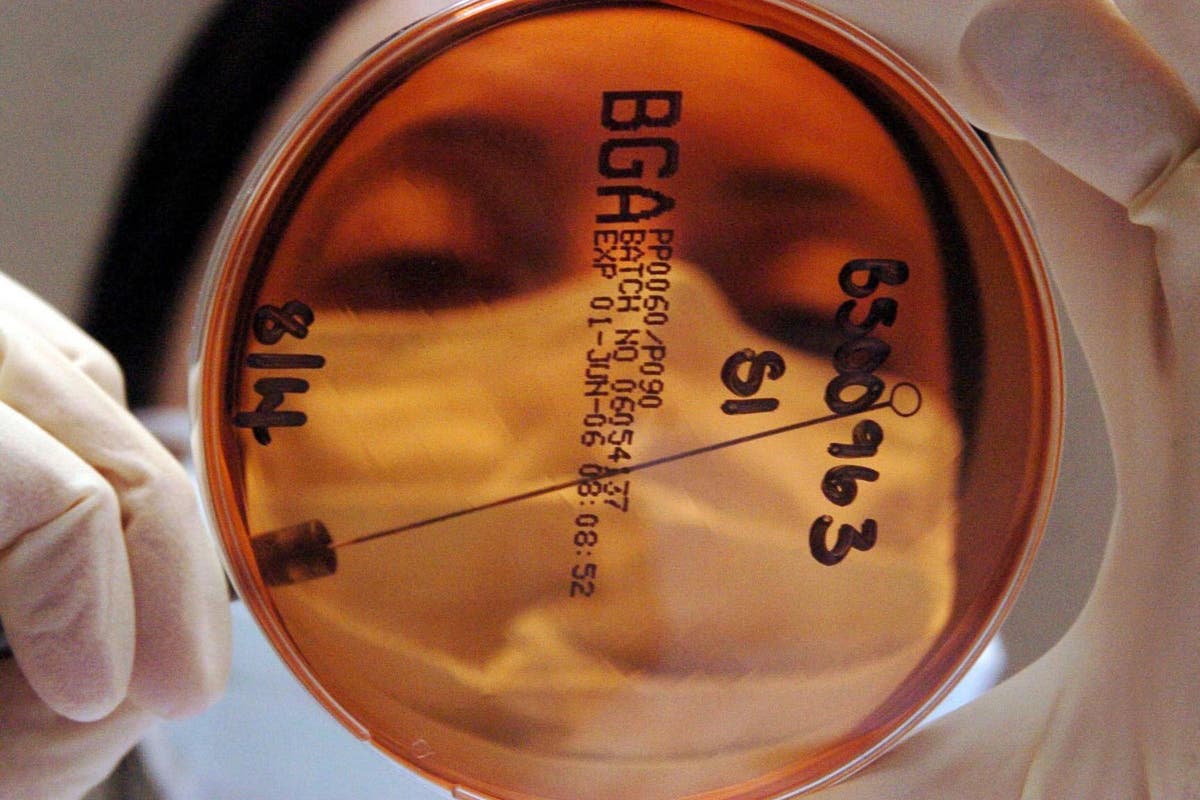
Scientists take first steps towards urine test for cancer

Hence then, the article about scientists take first steps towards urine test for cancer was published today ( ) and is available on INDEPENDENT ( United Arab Emirates ) The editorial team at PressBee has edited and verified it, and it may have been modified, fully republished, or quoted. You can read and follow the updates of this news or article from its original source.
Read More Details
Finally We wish PressBee provided you with enough information of ( Scientists take first steps towards urine test for cancer )
Last updated :
Also on site :
- Biden Loyalist: Platner’s Nazi Tat, Wife-Beating, Pedo App & Rape Fantasies Aren’t Just ‘Transgressions’
- Trump celebrates 80th birthday with a UFC fight at the White House as Americans pay the price for his Iran war
- Republican attorneys general urge EPA to classify mifepristone as water contaminant